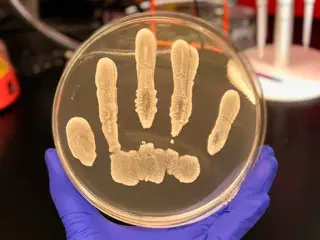

Un nuevo fármaco experimental duplica la tasa de supervivencia en el cáncer de páncreas
Juan Manuel Delgado
El elraglusib, que actúa sobre la proteína GSK-3 beta, combinado con quimioterapia, muestra resultados prometedores y reduce el riesgo de muerte en un 38% en pacientes.